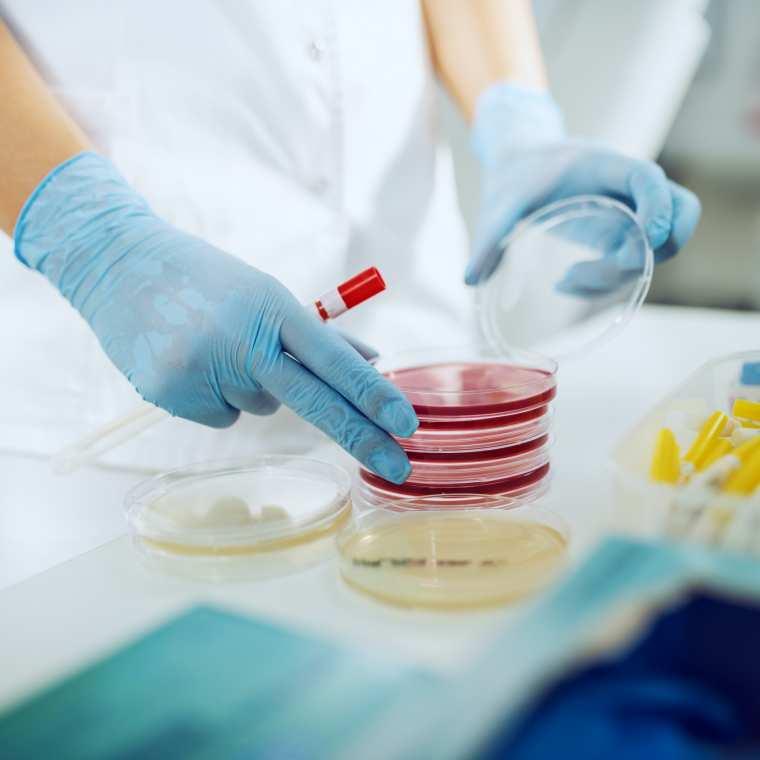

- tel: +381 11 30 16 492
- email: office@vicor.rs
- SERVIS
O kompaniji Vicor
VICOR d.o.o. je savremena kompanija koja se bavi uvozom i distribucijom medicinskih sredstava, veleprodajom ugradnog, medicinskog i laboratorijskog potrošnog materijala, aparata i instrumenata za laboratorijsku medicinsku dijagnostiku, fizikalnu medicinu i industrijsku kontrolu kvaliteta.
Naša priča
Mali tim ljudi, pre više od 20 godina, započeo je priču o Vicor-u, sa idejom o snabdevanju korisnika najkvalitetnijim medicinskim i laboratorijskim potrošnim materijalom, a kasnije i opremom. Pokretala nas je želja da pružimo pravu profesionalnu, ali i prijateljsku podršku u radu naših partnera i budemo deo rešenja za njihove svakodnevne probleme. Zato nam je prvi korak u kontaktu sa klijentom, kao i u daljoj saradnji sa njim, bio i ostao LIČNO ANGAŽOVANJE!

Naša vizija
Godine koje su sledile bile su svedok rasta Vicora u moderno organizovanu firmu koja danas broji preko 50 zaposlenih i nastavlja svoj razvoj konstantnim unapređenjem procesa i uslova rada, kvaliteta pruženih dobara i usluga, kao i edukacije zaposlenih. Nakon svega, i dalje ne smatramo da smo stigli na svoj krajnji cilj. Tu smo da svojim sadašnjim korisnicima olakšamo poslovanje, a budućim pokažemo da razvoj njihovog poslovanja ne mora da bude teška misija, ako pored sebe imaju pravog poslovnog partnera. Vicor je tu da bude i partner, i prijatelj u viziji njihovog razvoja.
Naši korisnici
Vicor sa ponosom sarađuje sa najrazličitijim korisnicima širom medicinskog i istraživačkog sektora. Naša posvećenost pružanju vrhunskih proizvoda i usluga omogućila nam je da izgradimo jaku mrežu korisnika koji se oslanjaju na nas kao pouzdanog partnera u zadovoljavanju njihovih potreba.
Zahvaljujući poverenju koje su nam ukazali, postali smo lideri u prodaji i distribuciji medicinske i laboratorijske opreme. Neprekidno radimo na jačanju naših veza i širenju naše zajedničke mreže kako bismo nastavili da pružamo vrhunske proizvode i usluge koje zadovoljavaju najviše standarde u regionu.
Ovo su samo neki od njih:
. . .- Klinički centri i bolnice: opšte bolnice, specijalizovane klinike i privatne medicinske ustanove oslanjaju se na nas kako bi obezbedili neophodnu opremu za dijagnostiku, terapiju i praćenje pacijenata.
- Privatne laboratorije: laboratorije koje se bave kliničkom analizom i dijagnostikom sarađuju s nama kako bi obezbedile visokokvalitetnu opremu koja im je neophodna za tačne, precizne i pravovremeno izdate rezultate. Biohemijski i hematološki analizatori, kao i koagulometri, urin analizatori i drugi aparati, pružaju im mogućnost za ispunjenje njihovih zahteva a sve u skladu sa potrebama pacijenata.
- Istraživačke laboratorije: Univerziteti, farmaceutske kompanije, biotehnološke firme i druge istraživačke organizacije koriste našu opremu za podršku svojim naučnim istraživanjima. Mikroskopi, centrifuge, PCR aparati, termo komore i drugi instrumenti koji su im neophodni za obavljanje eksperimenata i analiza dostupni su kod nas.
- Naši korisnici su i oni koji planiraju da započnu posao. Tu smo da pomognemo raznim savetima, podrškom i upoznavanjem sa najvažnijim segmentima poslovanja medicinske ustanove.
Šta nas izdvaja od drugih?
Poslovnost najvišeg nivoa, tačnost isporuke i kvalitet robe i servisa, su on što kompaniju Vicor izdvaja od ostalih. Konstantno smo na raspolaganju da svojim znanjem i iskustvom izađemo u susret i najzahtvenijim korisnicima, čija preciznost i pouzdanost u radu za nas predstavljaju imperativ.
Tehničku i servisnu podršku pružaju naši sertifikovanih inženjeri servisne službe, a stručni saradnici, svojim savetima, individualnim konsultacijama, inovativnim predlozima i stalnom podrškom, unapređuju rad naših klijenata.
Ono što nama i jeste najvažnije i na šta smo posebno ponosni jesu ljudi. Poznavanje svih problema i izazova sa kojima se suočavaju naši korisnici, razumevanje i neposrednost, razlog su zbog čega naši zaposleni uvek imaju poseban, drugačiji pristup vama i svemu što vam je potrebno. Upravo ste VI ti koji ćete prvi primetiti razliku kada uvidite da pored sebe imate podršku prijatelja, ne samo poslovnog partnera.
Jedan od ključnih razloga za naš uspeh leži u tome što posedujemo sve potrebne resurse interno. Kao jedinstvena celina, integrisali smo sve ključne aspekte poslovanja, uključujući prodaju, podršku, sektor za regulatorne poslove, logističku i finansijsku i knjigovodstvenu službu, distribuciju, servis i marketing sektor.
Ukupno gledano, naša sposobnost da integrišemo sve ove ključne aspekte poslovanja omogućava nam da pružimo celovito rešenje našim korisnicima. Bez potrebe za angažovanjem eksternih partnera, naši klijenti mogu biti sigurni da će dobiti visokokvalitetnu opremu, podršku i usluge na jednom mestu.